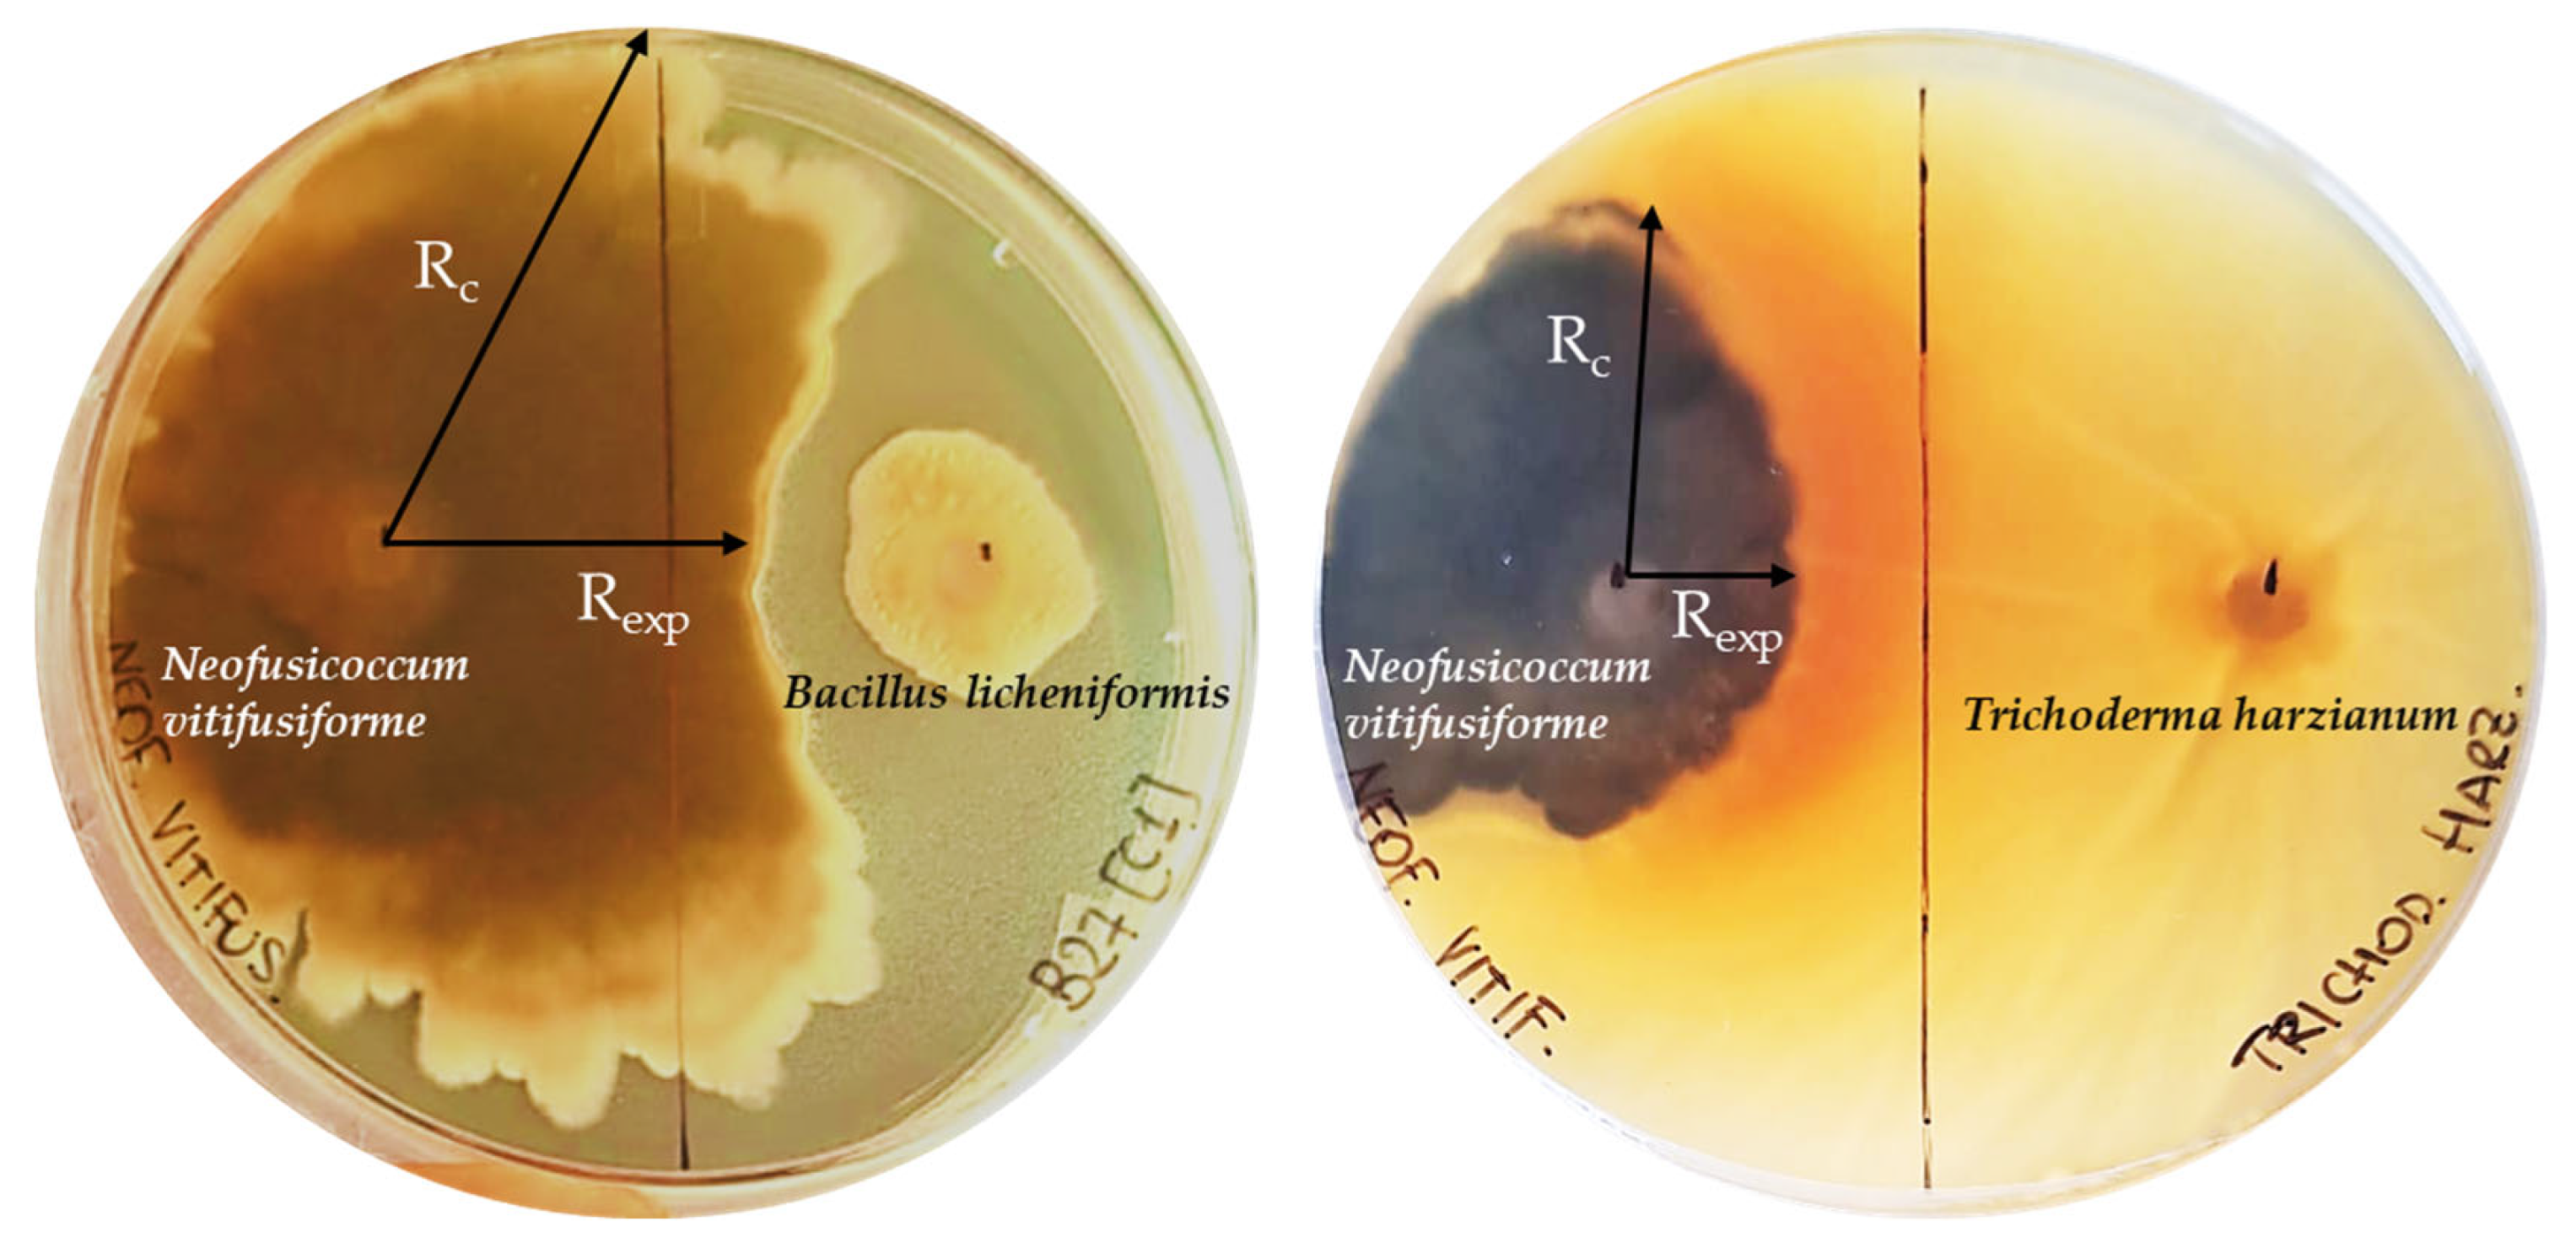
Microorganisms 13 01502 g005

Abstract
This study aims to identify the optimal conditions—host, plant material, seasonality, and agricultural practices—for isolating and developing a collection of culturable endophytic microorganisms to support sustainable Olea europaea L. cultivation. Samples were collected from three Sicilian olive cultivars (‘Nocellara del Belice’, ‘Nocellara Etnea’, and ‘Nocellara Messinese’) and six wild olive accessions across different phenological phases and under organic and conventional agronomic management. Endophytes were isolated from leaves and twigs using a culture-dependent approach, and their taxonomic diversity and plant-growth-promoting (PGP) traits were analyzed. A total of 133 endophytic isolates were identified, spanning bacterial (Proteobacteria, Firmicutes, and Actinobacteria) and fungal (Ascomycota and Basidiomycota) phyla. Wild olive trees contributed more than cultivated varieties to enriching the diversity and composition of culturable endophyte collection as well as twigs instead of leaves. Winter sampling allowed to implement the taxonomic genera of olive endophyte collection. Both farming systems favored an increase in the composition of microbial collection, though organic farming systems supported greater microbial richness. Functional analysis highlighted key PGP traits in a selection of bacterial isolates, including indole-3-acetic acid and siderophore production, nitrogen fixation, and antifungal activity. Bacillus spp. dominated enzymatic activities, such as amylase, protease, and lipase production, as well as antifungal activity against the olive fungal pathogen Neofusicoccum vitifusiforme. This research highlights the significant diversity and functional potential of Mediterranean olive endophytes. Our findings emphasize the role of native microbial communities as bio-inoculants, promoting plant growth, nutrient uptake, and disease resistance. These insights lay the groundwork for developing targeted olive-microbial consortia for biocontrol and stress tolerance applications.
1. Introduction
The plant microbiota—comprising bacteria, fungi, oomycetes, algae, protozoa, nematodes, and viruses—continuously co-evolves with its host, playing a crucial role in plant growth and health [1]. Among these microorganisms, plant growth-promoting endophytes (PGPEs) are particularly valuable, as they colonize internal plant tissues, enhancing biomass accumulation, nutrient acquisition (such as nitrogen, phosphorus, iron, etc.), and the production of beneficial secondary metabolites. PGPEs also contribute to seed germination, root and shoot development, and overall plant resilience by modulating the host immune system, improving tolerance to abiotic stressors and pathogens [2,3].
These beneficial effects are mediated by a range of bioactive compounds and enzymatic activities, including (i) phytohormones such as indole-3-acetic acid (IAA) and gibberellins, which regulate plant development; (ii) siderophores, which enhance iron bioavailability; (iii) phosphate-solubilizing molecules; (iv) trehalose, which improves drought and salt-stress tolerance; (v) hydrolytic enzymes that facilitate bacterial entry into plant tissues; (vi) 1-aminocyclopropane-1-carboxylic acid (ACC) deaminase, which reduces ethylene levels and mitigates abiotic stress; (vii) nitrogen-fixing enzymes; (viii) enzymes capable of degrading complex organic compounds; and (ix) antimicrobial compounds that suppress phytopathogens [4,5]. However, the effectiveness of endophytes depends on microbial strain, plant genotype, physiological state, environmental conditions, and external stressors, making plant-microbiota interactions highly dynamic and complex [6,7,8].
The olive tree (Olea europaea L.), a key species in Mediterranean agriculture, is increasingly vulnerable to biotic and abiotic stressors due to shifting climatic conditions and evolving cultivation practices [9]. Italy, the second-largest olive producer in Europe [10], possesses a rich genetic heritage, with 25 officially recognized cultivars in Sicily alone [11]. Despite the economic and ecological importance of olive cultivation, studies on the culturable microbial diversity of the olive phyllosphere remain limited [12,13,14,15]. Most research has focused on how climate, host genotype, plant organ specificity, and seasonal variation influence microbial communities, while investigations into beneficial microorganisms in Italian olive groves have largely concentrated on soil-dwelling microbiota [16]. To bridge these gaps, we investigated the culturable fraction of olive phyllosphere microbiota by maximizing the diversity of both plant hosts and environments, i.e., including wild and cultivated accessions of different varieties collected in Sicilian traditional olive districts.
Considering the loss of microbial diversity associated with domestication [17] and the positive influence of manure amendments on the plant-associated microbial community [18], we hypothesized that (a) wild olives harbor a higher endophytic diversity than cultivars, and (b) organic farming practices enhance microbial richness.
This study aims to identify the optimal conditions for establishing a functional microbial collection from the phyllosphere of Sicilian olive cultivars and wild olive trees. Using a culture-dependent approach, we assessed microbial diversity across different host types, plant organs, phenological stages, and farming systems. Selected bacterial isolates were characterized in vitro for their plant growth-promoting properties, enzymatic activity, and antagonistic potential against major olive pathogens, including Verticillium dahliae and Neofusicoccum spp. By linking microbial functionality to environmental and host-related factors, this research provides critical insights for the development of an optimized microbial collection, enabling targeted applications in sustainable olive production and biological control strategies.
2. Materials and Methods
2.1. Orchard Site and Sampling
Plant material was collected from five olive orchards (Table 1 and Supplementary Figure S1) under different pedo-climatic conditions, including mild winters and dry summers in southern Sicily, as well as rainfall and strong thermal fluctuations in suburban areas around Mount Etna in eastern Sicily. Three dual-purpose (table and olive oil use) cultivars (Olea europaea L. subsp. europaea var. europaea), namely ‘Nocellara del Belice’ (NB), ‘Nocellara Etnea’ (NE), and ‘Nocellara Messinese’ (NM), were selected from different sites listed in Table 1. Additionally, wild olive accessions (SYLV) were chosen from two sites within the Pisano Forest (SAC—Special Conservation Area, ITA090022), characterized by a lower humid meso-Mediterranean bioclimate and hosting a rich population of Olea europaea L. subsp. europaea var. sylvestris (Table 1). At each sampling site, leaves and twigs were collected from three randomly selected olive trees during four different periods corresponding to phenological phases: winter rest (WD, December 2021–February 2022), flowering (FL, May 2022), fruit set (FS, June–July 2022), and fruit maturation (MAT, October 2022).
Table 1.
List of olive trees, cultivars, and wild accessions with the corresponding sampling sites and farming systems; NB: ‘Nocellara del Belice’; NE: ‘Nocellara Etnea’; NM: ‘Nocellara Messinese’; SYLV: wild olive trees. A map of sampling sites is also available in Supplementary Figure S1.
2.2. Endophyte Isolation
Samples were collected from four distinct branches distributed across the four cardinal points of the canopy of each olive tree, handled with sterile tools, placed in sterile plastic bags, maintained at 4 °C, and processed within 48 h. Leaves and twig tips (7–8 cm) from each sample were separated and randomly divided into two distinct pools of 10 leaves and 6 twigs. Each pool was weighed, washed with tap water, and surface-disinfected through immersion in 70% (v/v) ethanol for 2 min, 3% (w/v) sodium hypochlorite for 3 min, and 70% (v/v) ethanol for 1 min, followed by three rinses of 1 min each in sterile distilled water (SDW). The disinfected samples were then ground in sterile mortars with 5 mL of SDW. Plant extracts (100 µL) were serially diluted and plated on Nutrient Agar (NA, Condalab) and Potato Dextrose Agar (PDA, Condalab) plates. A negative control was prepared by plating an equal volume of the final wash water onto the same media. Plates were incubated at 26 °C in the dark and observed daily. Total colonies were counted and the number of colony-forming units (CFUs) converted to log10 CFUs/g of fresh plant material. Bacterial and fungal colonies were initially grouped according to colony morphological features (shape, color, elevation, surface, margin, aerial mycelium, presence of exudate, and growth rate) and microscopic similarity, and at least two representative colonies of each morphotype for each organ and host sample were selected, purified, and maintained in pure cultures at −80 in glycerol (10–50% v/v).
2.3. Identification of Bacterial and Fungal Endophytes
Molecular identification was performed through sequence analysis of PCR-amplified bacterial 16S rDNA genes and fungal internal transcribed spacer (ITS1, 5.8S, ITS2) rDNA regions. Bacterial isolates were cultivated in Nutrient Broth (NB) medium and incubated at 28 ± 2 °C for 24 h. Bacterial genomic DNA was extracted from cell pellets resuspended in 500 µL of TE buffer, enzymatically lysed with Proteinase K (20 mg/mL), and purified using the phenol/chloroform/isoamyl alcohol (25:24:1) method [19]. The extracted DNA was amplified using universal primers (27f and 1492r) following the original PCR protocol [20].
Pure fungal cultures were obtained on PDA plates incubated for seven days at 28 ± 2 °C. Fungal genomic DNA was extracted from 200 µg of scraped aerial mycelium, disrupted with tungsten carbide beads in a Tissue Lyser II (Qiagen, Hilden, Germany) set at 30 Hz for 2 min, following a Cetyl Trimethyl Ammonium Bromide (CTAB) protocol [21]. DNA amplification was performed using the ITS5/ITS4 primer set [22], following the original PCR protocol with an annealing temperature of 56 °C. The amplified products were purified and sequenced by Eurofins Genomics (Ebersberg, Bayern, Germany).
Bacterial and fungal identification was performed using the highest identity score from BLAST 2.15.0 software of the National Center for Biotechnology Information (NCBI) against the NR database. Sequences were deposited in the GenBank database under accession numbers PP506680-PP506717, PV240332-PV240334, PP513240-PP513283, and PP513285-PP513302 (Supplementary Table S1). A percentage identity > 98% with NCBI sequences was accepted for species-level identification, while identities between 95% and 97% were classified at the genus level. Isolates with identity < 95% were designated as “unknown” [23].
2.4. Determination of Plant Growth Promotion Properties and Enzymatic Activities of Bacterial Isolates
The production of IAA was evaluated using a colorimetric technique by incubating 3 mL of a liquid culture in NB with L-tryptophan (100 mg/L) and incubated at 28 °C for 72 h with shaking. Cultures were centrifuged for 5 min at 15,000 × g and supernatants transferred to glass tubes. Color changing to pink (positive reaction) was verified following the addition of 4 mL of Salkowski’s reagent [24]. The amount of IAA was calculated by measuring the absorbance at 535 nm in a spectrophotometer (ASYS UVM-340 Microplate Reader, Biochrom, Ltd., Cambridge, UK), accordingly to a standard curve appropriately realized.
Siderophores production was evaluated in Chrome Azurol S (CAS) agar plates [25]. Aliquots (100 μL) of bacterial cultures were inoculated in the wells of the CAS plates and incubated for 7 days at 28 °C in darkness. Bacteria that produced siderophores showed an orange halo.
Phosphate solubilization was determined by the presence of a transparent halo around the bacterial cultures (100 μL) inoculated in wells of NBRIP plates (phosphate growth medium from the National Institute of Botanical Research) after 7 days at 28 °C [26].
Nitrogen fixation was assessed by plating strains in a nitrogen-free minimum medium (NFB; [27]) and incubating for 5 days at 28 °C. Bacterial growth indicated the possible ability of the bacteria to fix atmospheric nitrogen.
The formation of biofilms was determined by checking the adhesion capacity of the bacteria in microplates with 12 wells in NB at 28 °C, incubating for 4 days. After incubation, the biofilm formation was observed in the surface and/or bottom of the wells. Then, each well was stained for 20 min with 0.01% crystal violet [28] to evaluate the presence of a ring of biofilm around the well walls.
The ACC deaminase activity was performed as described by Penrose and Glick (2003) [29]. Briefly, bacterial cultures were incubated in a salts minimal broth added with ACC (5 mM) for 24 h at 28 °C by shaking. The α-ketobutyric acid produced was quantified using a standard curve with known concentrations at 540 nm in a spectrophotometer (ASYS UVM-340 Microplate Reader, Biochrom, Ltd., Cambridge, UK), and ACC deaminase activity was expressed in μmoles of α-ketobutyrate per mg of protein per hour.
Enzymatic activities were determined on plates incubated at 28 °C for 7 days, observing the formation of halo around the bacterial biomass. DNAse activity was determined by streaking the isolates on DNA agar plates revealed with 1 M HCl. Amylase activity was performed on starch agar plates (Scharlab, Barcelona, Spain) and revealed with 10 mL lugol. Protease and lipase activities were assessed in casein agar and Tween 80 media, respectively, as described by Harley and Prescott (2002) [30]. Pectinase and cellulase activities were examined as described by Elbeltagy et al. [31]. For pectinase activity, strains plated on ammonium mineral agar plates were revealed with 2% CTAB, and positive bacteria showed a halo. For cellulase activity, strains were plated on solid minimal medium supplemented with yeast extract (0.2%) and carboxymethylcellulose (1%). Plates were developed by covering the plate with 1 mg/mL Congo Red solution for 15 min and decolorizing with 1 M NaCl for 20 min. Finally, chitinase activity was performed as described by Mesa et al. [32] on agar plates containing minimal medium supplemented with colloidal chitin.
2.5. Dual Culture Plate Screening for Antagonistic Activity of Endophytic Members of Consortia
Five top-performing bacterial isolates that exhibited a higher number of plant-growth-promoting (PGP) properties (PGP properties ≥ 3 and enzymatic activities ≥ 2), along with the only isolate presenting chitinase activity, were selected. The six isolates were tested in vitro for their antifungal activity against olive fungal pathogens: two no-defoliating strains of Verticillium dahliae (Vd-LT and Vd-CS), one strain of Neofusicoccum parvum (Np-P4), and one strain of Neofusicoccum vitifusiforme (Nv-P3). Three replicate plates were prepared for each bacterial isolate. For screening, round agar plugs of 5 mm diameter of the filamentous fungi were obtained from the margins (active growth zone) of young mycelia grown on PDA and placed at a distance of 21 mm away from the Petri dish edge (standard 90 mm Petri dishes) with fresh nutrient agar. One hundred microliters of bacterial suspension (~106 cells/mL) were inoculated 45 mm away from the fungal plug on the opposite side of the plate. Negative control plates were inoculated only with the filamentous fungi, while a strain of Trichoderma harzianum S3, a fungus commonly used as biocontrol agents [33], was inoculated instead of bacteria as positive control. The plates were incubated for 42 days at 25 °C in the dark. Mycelial growth was observed weekly, and images were captured to record the growth. The inhibition percentage was calculated as [(Rc-Rexp)/Rc] × 100%, where Rc represents the longest distance of fungal mycelium from the inoculated fungal plug, and Rexp is the horizontal distance from the inoculated fungal plug towards the bacterial colony, which shows the inhibitory effect [34,35].
2.6. Data Analysis
A non-parametric approach was adopted to analyze the culturable endophyte occurrence in leaves and twigs of different olive varieties and wild accessions during the four phenological phases. To investigate the differences in CFU/g, the Kruskal–Wallis statistic with adjustment for ties [36] was adopted and implemented on Minitab statistical software version 22.1.0 [37].
Richness and evenness were calculated to determine the α-diversity of the culturable fungal and bacterial endophytes identified at genus level in different hosts under several environmental factors. To carry out diversity analyses, the PAST 4.17 software tool [38], version 4.17, was used, estimating the diversity indices and the species rarefaction curves in leaves and twigs for each phenological phase based on the Simpson index (1/D). For diversity analyses, only the identified taxonomic genera were considered, excluding the “unknown”.
β-diversity was examined by means of non-metric multidimensional scaling (NMDS), using the Bray–Curtis coefficient and the Jaccard indexes as similarity measures. Analyses were performed using the PAST 4.17 software, and the quality of the results was visualized in the Shepard plots, accepting stress values ≤ 0.2 as goodness of fit. To assess significant differences among endophyte community groups obtained by NMDS plots, p-values (significance assumed for p ≤ 0.05) were generated by one-way analysis of similarity (ANOSIM) from Bray–Curtis matrices automatically computed in PAST 4.17 software. To assess which taxa are primarily responsible for a difference between groups of samples, the similarity percentage (SIMPER) analysis was implemented on PAST 4.17 software.
Venn diagrams were made using the opensource component for web environment Jvenn (available online: http://jvenn.toulouse.inra.fr, accessed on 30 April 2025).
To obtain information about the functional diversity of fungal strains, the FUNGuild database was used to estimate the trophic modes and guilds of fungi [39]. This tool allows to predict the following primary fungal lifestyles: pathotroph: receiving nutrients at the expense of the host cells and causing disease; saprotroph: receiving nutrients by breaking down dead host cells; symbiotroph: receiving nutrients by exchanging resources with host cells.
3. Results
3.1. Culturable Endophyte Occurrence in Sicilian Olive Cultivars and Wild Accessions
The presence of bacterial and fungal colonies on NA and PDA media increased during the incubation period, and most of them appeared within 10 days. No colonies were obtained from any dilutions. The absence of colonies was observed on some NA and PDA plates regardless of olive samples, organs and phenological phases, probably due to the low concentration and erratic distribution typical of plant endophytes. Considering the plant material, most of colonies were recovered from twigs compared to occasional microbial isolation from leaves. Twigs enabled the isolation of endophytes from more olive trees along all phenological phases (Figure 1A,B) as well as farming systems (Figure 1C,D).
Figure 1.
Box plots showing total microbial counts (log10 CFU/g) of leaf (A,C) and twig (B,D) endophytes isolated from the different cvs. ‘Nocellara del Belice’ (NB), ‘Nocellara Etnea’ (NE), and ‘Nocellara Messinese’ (NM) and Sicilian wild olive trees (SYLV) during the four phenological phases (WD, winter rest; FL, flowering; FS, fruit set; MAT, fruit maturation) (A,B) and farmed under organic (ORG) and conventional (CONV) management and no agricultural practices (NONE) (C,D). The central horizontal bars are the medians. The central symbol X corresponds to average values, and the red vertical lines are the standard deviations. Points above and below the whiskers’ upper and lower bounds are outliers.
Within cultivars, the occurrence of culturable endophytes was significantly influenced by twig samples in ‘Nocellara del Belice’ (p = 0.036), ‘Nocellara Messinese’ (p = 0.007), and wild olive accessions (p = 0.038) compared to leaves. The highest value of total microbial count in twigs was observed during fruit maturation in ‘Nocellara del Belice’, ‘Nocellara Etnea’, as well as wild olive trees and during flowering in ‘Nocellara Messinese’ (Figure 1B). Regarding farming systems, samples from olive trees under organic management showed a higher microbial occurrence (Figure 1C,D), which varied significantly in samples from ‘Nocellara Etnea’ (p = 0.001) compared to those under conventional management. Among phenological phases, no significant differences were observed in olive cultivar and wild olive tree total microbial count.
3.2. Diversity of Culturable Endophytes
From olive leaves and twigs collected during all phenological phases, a total of 133 phenotypically different endophytic bacterial and fungal isolates were selected and identified by 16S rRNA gene and ITS sequencing analysis, respectively. Sequence lengths varied from 474 to 1425 bp for 16S rRNA region and from 417 to 651 bp for the ITS region (Supplementary Table S1).
The 60 bacterial isolates identified were affiliated to three phyla (Actinobacteria, Firmicutes, and Proteobacteria) and mainly associated most with the genera Bacillus (43.3%), Staphylococcus (18.3%), and Sphingomonas (10.0%) (Figure 2). The 68 fungal isolates identified were assigned to two phyla (Ascomycota and Basidiomycota) and affiliated to the genera Quambalaria (17.4%), Alternaria (10.1%), and Biscogniauxia (8.7%) (Figure 3). The five isolates that showed a sequence identity ≤ 94.7% were excluded from analyses (Supplementary Table S1). The microbial diversity (high or low) found in each sample was independent of the overall number of microorganisms present, regardless of host, organ, phenological phase, or farming system.
Figure 2.
Relative abundance of endophytic bacterial genera in hosts (A), phenological stages (B), plant organs (C), and farming systems (D) of olive trees cvs. ‘Nocellara del Belice’ (NB), ‘Nocellara Etnea’ (NE), and ‘Nocellara Messinese’ (NM) and Sicilian wild olive trees (SYLV).
Figure 3.
Relative abundance of endophytic fungal genera in hosts (A), phenological stages (B), plant organs (C), and farming systems (D) of olive trees cvs. ‘Nocellara del Belice’ (NB), ‘Nocellara Etnea’ (NE), and ‘Nocellara Messinese’ (NM) and Sicilian wild olive trees (SYLV).
Considering olive hosts, Sicilian wild olive trees contributed most to the diversity of bacterial and fungal endophyte collection (Figure 2A and Figure 3A) and significantly to microbial composition (R = 0.562; p = 0.008) compared to cultivated varieties that showed a more homogeneous endophytic composition (few different dominant genera with individuals uniformly distributed), with minor differences (Table 2; Supplementary Figure S2). Rarefaction curves showed that the probability to enrich the microbial collection of endophytes can be further increased by analyzing a larger number of wild olive samples, while for cultivated olive trees, the plateau seems to be reached (Supplementary Figure S3).
Table 2.
Diversity indices of endophytes associated with leaves (L) and twigs (T) of different olive hosts (NB, ‘Nocellara del Belice’; NE, ‘Nocellara Etnea’; NM, ‘Nocellara Messinese’; SYLV, wild olive accessions).
Nine microbial genera (Acinetobacter, Chaetomium, Eurotiomycetes, Peniophora, Pleosporineae, Preussia, Priestia, Providencia, and Tritirachium) derived exclusively from wild plants (Figure 4A). Endophytes belonging to ten genera, i.e., Bacillus, Methylobacterium, Methylorubrum, Sphingomonas, Staphylococcus, Biscogniauxia, Cladosporium, Diaporthe, Penicillium, and Quambalaria, were isolated both from wild olive accessions and at least one of the three cultivars of ‘Nocellara’, representing ~25% of the endophytic communities (Supplementary Table S1). At species level, the bacterial endophytes Ectobacillus funiculus, Pseudomonas savastanoi, and Streptomyces bryophytorum and the fungal ones, namely Aspergillus stella-maris and Cladosporium sphaerospermum, were isolated only from leaf samples of the cultivar ‘Nocellara del Belice’, which clustered separately from the samples of other cultivars (Supplementary Figure S2A,B). Although differences in pairwise comparisons of microbial communities from different hosts were not significant (p > 0.05), the SIMPER analysis showed that the species of the genus Bacillus and secondarily those of the genus Pyronema and the species Sphingomonas paucimobilis contributed greatly to determining the differences among hosts, influencing more the diversification of isolation of culturable olive endophytes. Despite this diversity, a putative microbial core, defined as the community systematically associated with a given host plant [40], of culturable endosphere-associated microorganisms from Sicilian olive trees can be attributed to the presence of the genera Bacillus, Staphylococcus, and Quambalaria.
Figure 4.
Venn diagram of shared and specific microbial genera from different cvs. ‘Nocellara del Belice’ (NB), ‘Nocellara Etnea’ (NE), and ‘Nocellara Messinese’ (NM) and Sicilian wild olive trees (SYLV); (A) phenological phases (B), plant organs (C), and farming systems (CONV, conventional; ORG, organic) (D).
In almost all phenological phases, microbial isolates from wild olive trees enriched culture collection diversity and composition more than those from cultivated varieties (Figure 2B and Figure 3B, Supplementary Table S2). Among all samples, the highest number of microbial genera was isolated during the winter rest (Figure 4B), with a prevalence of fungal endophytes. The endophytic genera Bacillus, Quambalaria, and Staphylococcus were isolated during all sampling periods.
A wider diversity of endophytic isolates was reached in twigs rather than leaves both along all phenological phases and different olive hosts (Table 2 and Supplementary Table S2). Twig samples were richer on genera (Figure 2C, Figure 3C, and Figure 4C); about 35.7% of bacterial (Acinetobacter, Frondihabitans, Kocuria, Priestia, and Providencia) and 55.5% of fungal (Alternaria, Acremonium, Chaetomium, Diaporthe, Dydimella, Elsinoe, Geomyces, Nemania, Neosetophoma, Paraconiothyrium, Peniophora, Peziza, Phoma, Stemphylium, and Tricharina) genera were isolated only from that plant material, mainly from cv. ‘Nocellara Messinese’. More than 20% of both bacterial and fungal genera were isolated from only leaves (Ectobacillus, Pseudomonas, Paenibacillus, Endoconidioma, Lybertasomyces, Preussia, Pleosporinae, Sordariomycetes, Pezizaceae, and Tritirachium). Almost 30% of microbial genera (Bacillus, Methylobacterium, Methylorubrum, Sphingomonas, Staphylococcus, Streptomyces, Aspergillus, Biscogniauxia, Cladosporium, Penicillium, and Quambalaria) were recovered from both plant organs.
The microbial diversity of the culturable endophytic collection was considerably increased by the contribution of microbial communities from samples of the organically farmed cv. ‘Nocellara del Belice’ as well as cultivars ‘Nocellara Etnea’ and ‘Nocellara Messinese’, farmed under conventional practices (Supplementary Table S3). Regarding taxonomical genera, the endophyte collection was enriched both from samples collected under organic (12) and conventional (13) practices (Figure 4D). The bacterial genera (Ectobacillus, Kocuria, Methylobacterium, and Pseudomonas) and fungal genera (Aspergillus, Geomyces, Nemania, Pezizaceae sp., Pyronema, Stemphylium, and Tricharina) associated with organic farming systems were different from the genera (bacterial: Frondihabitans, Methylorubrum, and Paenibacillus; fungal: Biscogniauxia, Cladosporium, Diaporthe, Elsinoe, Endoconidioma, Neosetophoma, Paraconiothyrium, Peziza, and Sordariomycetes sp.) associated with conventional managements (Figure 2D and Figure 3D). Only seven microbial genera (Alternaria, Bacillus, Penicillium, Quambalaria, Sphingomonas, Staphylococcus, and Streptomyces) were found to be widespread in cultivars farmed under both agricultural practices. Endophyte isolates from samples of each cultivar under organic management were taxonomically different from those isolated from conventional management, but no clear differentiation and no significant dissimilarities of two groups (ORG and CONV) was observed by NMDS ordination (Supplementary Figure S2C,D) and ANOSIM analysis. Bacillus, Sphingomonas, Alternaria, and Quambalaria from cv. ‘Nocellara del Belice’; Staphylococcus and Quambalaria from cv. ‘Nocellara Etnea’; and Bacillus and Staphylococcus from cv. ‘Nocellara Messinese’ were the microbial genera found in common between the two farming systems.
3.3. Characterization of Endophytic Bacteria from Olive Leaves and Twigs
3.3.1. Plant Growth-Promotion Properties and Enzymatic Activities
A total of 45 bacterial isolates were characterized to evaluate the presence of plant growth-promotion traits, and about 90% of them, representing those with greater growth capacity in vitro, showed PGP properties (Supplementary Table S4) and enzymatic activities (Supplementary Table S5). All isolates showed at least one of the screened characteristics, and 65% of them exhibited from five to ten PGP traits concurrently. The most common PGP properties were siderophore production (80%), biofilm formation (77.5%), and nitrogen fixation (65%). Bsp_GIAL05R strain (Bacillus sp.) showed the highest production of siderophores according to the diameter of the halo in CAS medium (Supplementary Table S4), and Bm_GIAL02R (Bacillus megaterium), Msp_SYLV02F (Methylobacterium sp.), and Pv_SYLV05R (Providencia vermicola) were the best phosphate solubilizers (Supplementary Table S4). A high number of isolates (26) were able to grow in N-free medium. The strain Pv_SYLV05R (Providencia vermicola) produced the highest concentration of IAA, more than 9 mg/L (Supplementary Table S4). Bacterial isolates did not show biological ACC deaminase activity in vitro. Among the seven enzymatic activities studied, amylase (57.5%), lipase (52.5%), and DNase (52.5%) were the most represented (Supplementary Table S5). Protease synthesis was found in 15 endophytes, and four strains of Bacillus genus (Bsp_NMC03R, Bsp_NMC03F, Bm_GIAL02Rb, and Bsp_NEB03RIII) showed a strong activity (Supplementary Table S5). Cellulase, pectinase, and chitinase activities were detected in a low number of isolates (three to seven).
3.3.2. Antagonistic Activities
Among the screened bacterial isolates, Bacillus licheniformis Bl_SYLV02R displayed inhibitory activity against the fungal pathogen Neofusicoccum vitifusiforme (Nv-P3) in dual-plate assay (Figure 5). A mycelial inhibition percentage equal to 40.3% was recorded compared to that of the positive control, explained by the 60% inhibition by Trichoderma harzianum S3 against the same pathogenic fungus (Supplementary Table S6). It is noteworthy that the other different tested species within the Bacillus genus (Bacillus sp. and Bacillus marisflavi) did not exhibit the same inhibition capability. No inhibitory activity was observed against the two no-defoliating strains of Verticillium dahliae (Vd-LT and Vd-CS) and the fungus Neofusicoccum parvum (Np-P4) by Bacillus licheniformis Bl_SYLV02R or by the other bacterial isolates against all the pathogenic fungi considered.
Figure 5.
Representation of the dual culture assay showing antifungal activity of Bacillus licheniformis Bl_SYLV02R and Trichoderma harzianum S3 against the fungal pathogen Neofusicoccum vitifusiforme (Nv-P3) and how the inhibition was measured. Rc represents the longest distance of fungal mycelium growth from the inoculated fungal plug, and Rexp is the horizontal distance from the inoculated fungal plug towards the screened isolates.
3.4. Trophic Mode of Endophytic Fungi
Fungal taxonomic functional analyses by FUNGuild classified the fungal strains into different trophic modes (Supplementary Table S7). The most common trophic mode was pathotroph–saprotroph–symbiotroph (41.2% of identified isolates), followed by pathotroph (13.2%) and saprotroph (11.7%) (Supplementary Table S7). The main trophic mode was mainly represented by endophytes, animal and plant pathogens, and wood saprotrophs (Supplementary Table S7). The pathotroph group was exclusively represented by the plant pathogen Quambalaria cyanescens, most frequently isolated under conventional farming. The species Endoconidioma populi, Geomyces sp., Libertasomyces platani, Nemania serpens, Paraconiothyrium brasiliense, and Preussia minima were classified as wood and plant saprotroph. The endophytes Neosetophoma sp., Pyronema sp., and Tricharina sp. and the dung saprotrophs Peziza sp. and Pezizaceae sp. belonged to the saprotroph–symbiotroph group and were isolated only during the winter rest and mostly under organic farming systems.
4. Discussion
The beneficial interaction between plants and their phyllosphere endophytes is well recognized, yet relatively few studies have explored the functional potential of endophytic communities associated with olive trees in Mediterranean environments. This study aimed to establish a collection of beneficial microorganisms for potential application in olive cultivation to enhance plant tolerance to abiotic and biotic stresses. Focusing on the culturable fraction of the olive endophytic microbiota, we leveraged the plant’s natural selection of symbiotic partners to isolate microorganisms with multiple PGP traits, ultimately identifying candidates for future bioinoculant development. To maximize microbial diversity, we sampled different olive cultivars representative of the local germplasm, cultivated under varying pedoclimatic conditions and either organic and conventional farming systems, and including wild olive accessions, across different phenological stages. A sampling protocol including the minimal standard number of biological replicates (three olive trees) was adopted, as applied in similar studies [41]. To recover the culturable fraction of microbial communities, we prepared leaf and twig pools prior to surface disinfection. This procedure is a standard method for isolating endophytes from woody crops [42], ensuring efficient sample processing within 24 h. It is important to note that this work does not seek to provide a comprehensive overview of the entire olive endophytic microbiota but rather to define optimal conditions for exploring the culturable fraction associated with some of the most widespread Sicilian varieties, identifying potential key taxa under different agroecological conditions.
For microbial isolation and maintenance, two general-purpose media (NA and PDA) were selected as widely used to isolate endophytes from plants [13,43,44,45,46,47,48]. As highlighted by Eevers et al. [49], complex media containing glucose and yeast extract foster higher endophyte cultivability than minimal media. Despite this, colony counts remained low across both media, irrespective of sample origin. Isolation efficiency likely depends not only on culture conditions and sterilization protocols but also on the intrinsic rarity, uneven distribution, and varied growth capacities of plant endophytes under aseptic conditions [50]. Moreover, fewer colonies are generally expected when surface disinfection is applied on plant tissues prior to strain isolation compared to soil samples. The use of additional selective, enriched, as well as oligotrophic media could improve future recovery rates as well as allowing the isolation of slow-growing taxa.
Considering that a species-level identification needs to combine morphological and muti-loci phylogenetic analyses [51], particularly for bacterial and fungal isolates, identification was limited at genus level for diversity analyses. The single target molecular identification used in this work did not allow us to clarify the taxonomic position of “unknown” isolates, which could represent novel taxa beneficial to the olive host. Future phylogenetic studies could better define their taxonomic position. Lacking sufficient genetic information and experimental evidence for pathotroph isolates, it was not possible to evaluate their real pathogenicity.
Many isolates recovered in this study have been previously reported as olive endophytes with plant-beneficial properties [14,46,52,53,54,55]. Notably, genera such as Ectobacillus, Geomyces, and Tritirachium were identified in olive trees for the first time, though they have been described as endophytes in other plant species [52,56]. According to the literature and based on our results, the isolates Ef_GIAL02F, Geosp_NMB03R, and Tritb_SYLV06F could play a role in thermal regulation, adaptation, and plant protection through enzyme and antibiotic production. The microbiota of Sicilian olive cultivars was predominantly composed of Proteobacteria, Firmicutes, and Actinobacteria, alongside fungal members of the Ascomycota phylum. Similar profiles have been reported in previous studies on Mediterranean olive trees [14,57,58], with Proteobacteria—particularly Pseudomonadales—frequently dominating, along with Actinobacteria, Firmicutes, Bacteroidetes, and other Proteobacteria isolated from cultivated and wild olive xylem sap [57]. Similarly, a higher prevalence of Proteobacteria was observed in Spanish cultivars and Portuguese wild olive trees [58]. The recovered fungal community was rich and largely composed of Dothideomycetes and Sordariomycetes, in agreement with earlier findings on Portuguese and Spanish olive orchards [13,59].
By accounting for host type (cultivated vs. wild), plant organs, phenological stages, and farming systems, this study sought to identify optimal conditions to build a representative collection reflecting the natural diversity of olive endophytes. Previous research by Müller et al. [58] compared the microbiota of cultivated and wild olive trees across Mediterranean regions, revealing that both genotype and geographical origin shape bacterial endophyte communities. Their analysis showed that wild olives clustered with cultivars from the same region, yet distinct taxonomic groups differentiated cultivated from wild trees. Our findings align with this pattern: Sicilian wild olive accessions formed distinct groupings compared to domesticated varieties while maintaining a closely related microbiota characterized by the presence of the class Eurotiomycetes, the family Pleosporineae, and the genera Acinetobacter, Chaetomium, Peniophora, Preussia, Priestia, Providencia, and Tritirachium. This result supports the hypothesis that domestication has progressively reduced microbial biodiversity. Historically, the selection of cultivated plants has prioritized agronomic and productive traits, often overlooking their capacity to establish beneficial relationships with soil and plant-associated microorganisms. Modern varieties, bred for high yields under intensive management, may have lost traits involved in hosting growth-promoting and pathogen-antagonistic endophytes. In contrast, wild relatives typically maintain richer and more diverse microbial communities [17]. Despite this, a conserved “core” microbiota persists across both wild and cultivated olives, which is functionally essential for plant fitness through genes acquired by evolutionary selection [60]. Within this core, the keystone taxa, i.e., highly connected taxa that influence community structure and function irrespective of their abundance across space and time [61], play a crucial role in ecosystem stability, nutrient cycling, pathogen suppression, and plant health [40]. Meanwhile, less abundant and transient satellite taxa contribute to disease resistance, resilience, and functional redundancy [62]. In our study, while ‘Nocellara’ and wild olive trees shared a core microbiota represented by Bacillus, Staphylococcus, and Quambalaria, wild accessions harbored greater microbial diversity, likely reflecting their adaptation to more heterogeneous and unmanaged environments.
Regarding plant organs, twigs hosted a higher number of taxa than leaves, a trend well documented across plant species. A meta-analysis by Harrison and Griffin [63] confirmed the predominance of endophytic fungi and bacteria in woody stems over other tissues. This was also evident in our study, with most culturable fungal species isolated from twigs, likely due to the richer presence of structural carbohydrates that promote fungal colonization [64]. Seasonal variation in olive endophytic communities remains poorly explored [12,46,65]. In line with Abdelfattah et al. [65], we recorded peak species richness and diversity during the winter rest period, dominated by fungal isolates—a pattern also reported for other Mediterranean woody crops [44]. According to results reported by Gomes et al. [13], climatic conditions typical of Sicilian winters, including higher winds, rainfall, and marked temperature–humidity fluctuations, likely enhance microbial dispersal and colonization. Notably, microbial composition shifted during sampling, favoring Bacillus and pigmented taxa, groups widely acknowledged for their stress tolerance and ecological versatility (mesophilic nature and endospore formation), making them valuable biofertilizers [66,67,68]. Most studies on farming practices and plant microbiota have focused on soil communities, but relatively few have addressed endophytes under different cultivation systems. Rhizosphere diversity is known to depend on soil properties, plant species, and management system, often increasing under organic practices [69]. Supporting this, Sofo et al. [70] and Wentzien et al. [18] found higher microbial abundance and diversity in organic olive orchards. Although focused on phyllosphere endophytes, our work also revealed greater microbial richness and abundance among plants under organic management.
While studies have begun to describe the olive root microbiome and its role in enhancing plant physiology [53,71,72,73], knowledge of the functional traits of olive phyllosphere endophytes remains limited. In this study, bacterial endophytes exhibited multiple PGP traits, including siderophore production, biofilm formation, auxin (IAA) synthesis, nitrogen fixation, and hydrolytic enzyme activity. Iron is a key nutrient for plant metabolism [74,75]. Microorganisms assist in its acquisition by producing siderophores that chelate ferric iron [76]. In our collection, 76.2% of bacterial isolates produced siderophores, with Bacillus, Sphingomonas, and Staphylococcus, mainly isolated from organic management, being predominant. While siderophore production by Bacillus and Staphylococcus has been documented in the olive rhizosphere [73], this is the first report of siderophore-producing Sphingomonas endophytes in olives, expanding their documented plant-beneficial roles [77]. Over 80% of isolates formed biofilms, with Sphingomonas, Bacillus, Providencia, and Kocuria showing the strongest capacity, in agreement with their known contribution to stress resilience and crop productivity [78,79]. Auxin IAA production was observed in 38% of isolates mostly collected in organic olive orchards and wild accessions, with Priestia, Bacillus, and Providencia being the most active producers. These findings are consistent with reports associating these genera with plant growth promotion, nitrogen fixation, and biocontrol activities against phytopathogenic nematodes and fungi [80,81,82,83,84,85]. Nitrogen fixation capacity was demonstrated by over 60% of isolates, including Acinetobacter, Bacillus, Paenibacillus, Priestia, Pseudomonas, Sphingomonas, and Staphylococcus, which are generally found regardless of management practices. These genera have previously been recognized as nitrogen fixers and potential biofertilizers [77,86,87,88,89]. Hydrolytic enzymes such as DNase, amylase, cellulase, chitinase, lipase, protease, and pectinase, involved in microbial colonization and plant protection, were widely produced among isolates. Bacillus showed the greatest enzymatic activity, followed by Frondihabitans, Paenibacillus, Pseudomonas, and Sphingomonas. Bacillus and Pseudomonas are the most prevalent PGP bacteria for enzymatic activities, with Bacillus-based biostimulants being widely commercialized due to their efficient metabolite synthesis [90]. The ecological role of Bacillus endophytes can include mechanisms of competitive exclusion such as resource competition, competition for attachment sites, and the production of antimicrobial compounds. The dominant presence of the genus Bacillus could be attributed to its ecological trade-offs as well as to selective recruitment by the host. Bacillus protein toxins and metabolites enhance colonization while exerting antagonistic effects on plant pathogens and insect pests [91,92]. Antifungal, antibacterial, and algicidal activities of siderophores are well documented [93,94,95,96,97]. Bacillus licheniformis lipopeptides, cell lytic enzymes, and siderophores contribute to the inhibition of pathogenic fungi [98,99]. In this study, Bacillus Bl_SYLV02R, characterized by siderophore and biofilm production as well as multiple enzymatic activities, showed significant antifungal activity against the olive pathogen Neofusicoccum vitifusiforme. Further studies are warranted to elucidate the mechanisms underlying this antifungal capacity and to assess the performance of these PGP isolates in planta, both individually and as microbial consortia.
5. Conclusions
In conclusion, wild olive trees, twig samples, and winter sampling were the optimal conditions to build a variegated collection of Sicilian olive culturable endophytes. Twigs hosted significantly higher endophyte abundance than leaves, and uncultivated olive trees could be considered as custodians of higher biodiversity. Organic management of olive yards seems promising for a richer functional endophyte collection, although further studies should be performed. Potential plant growth-promoting features for nutrient uptake, plant growth promotion, and protection against fungal diseases were demonstrated by bacterial endophytes, which would improve the overall fitness of the host plants.
The potential role of these Sicilian olive endophyte communities needs to be further investigated, evaluating their possible use as native microbial consortia in sustainable cultivation practices. Future applications for sustainable agriculture could be enhanced by integrating the native microbial communities of both cultivated and wild olives, selecting microbial consortia for plant growth promotion, biocontrol, and tolerance/resistance to biotic stresses.
Supplementary Materials
The following supporting information can be downloaded at https://www.mdpi.com/article/10.3390/microorganisms13071502/s1. Figure S1: Sampling sites; Figure S2: NMDS plots; Figure S3: Rarefaction curves; Table S1: Endophyte molecular identification; Table S2: Diversity indices during phenological phases; Table S3: Diversity indices in farming systems; Table S4: PGP properties; Table S5: Enzymatic activities; Table S6: Antagonistic abilities; Table S7: Functional diversity of fungal endophytes isolated from Sicilian olive tree, according to FUNGuild database.
Author Contributions
Conceptualization, D.C., F.C., T.C. and D.P.; methodology, D.C., D.P. and S.N.-T.; validation, D.C., D.P., S.B. and S.N.-T.; formal analysis, D.C. and S.B.; investigation, D.C. and D.P.; resources, D.C., F.C. and D.P.; data curation, D.C.; writing—original draft preparation, D.C.; writing—review and editing, D.C., S.B., S.N.-T., P.Q., F.C., T.C. and D.P.; visualization, D.C. and F.C.; supervision, D.C. and D.P.; project administration, D.C. and D.P. All authors have read and agreed to the published version of the manuscript.
Funding
This research was partially funded by the “BioMemory-Network of scientific collections for bio-monitoring, biodiversity conservation, agri-food and environmental sustainability, and well-being” project (https://biomemory.cnr.it), funded by the Department of Biology, Agriculture, and Food Sciences (DiSBA) of the National Research Council of Italy (CNR), project no. SAC. AD002.173 and by “Project IR0000032—ITINERIS, Italian Integrated Environmental Research Infrastructures System” (D.D. n. 130/2022—CUP B53C22002150006) Funded by EU—Next Generation EU PNRR—Mission 4 “Education and Research”—Component 2: “From research to business”—Investment 3.1: “Fund for the realisation of an integrated system of research and innovation infrastructures”.
Institutional Review Board Statement
Not applicable.
Informed Consent Statement
Not applicable.
Data Availability Statement
The original data presented in the study are openly available in the GenBank NCBI at https://www.ncbi.nlm.nih.gov/nuccore/PP506680.1/, accessed on 22 June 2025.
Acknowledgments
The authors thank the olive farm owners Giuseppe Cicero, Pasquale Consoli, Salvatore Scuderi, and Raimondo Triolo for making the plant material available. The authors thank Francesca La Bella and Antonio Motisi for technical support.
Conflicts of Interest
The authors declare no conflicts of interest.
References
- Mesny, F.; Hacquard, S.; Thomma, B.P. Co-evolution within the Plant Holobiont Drives Host Performance. EMBO Rep. 2023, 24, e57455. [Google Scholar] [CrossRef] [PubMed]
- Medison, R.G.; Tan, L.; Medison, M.B.; Chiwina, K.E. Use of Beneficial Bacterial Endophytes: A Practical Strategy to Achieve Sustainable Agriculture. AIMS Microbiol. 2022, 8, 624–643. [Google Scholar] [CrossRef] [PubMed]
- Ali, M.A.; Ahmed, T.; Ibrahim, E.; Rizwan, M.; Chong, K.P.; Yong, J.W.H. A Review on Mechanisms and Prospects of Endophytic Bacteria in Biocontrol of Plant Pathogenic Fungi and Their Plant Growth-Promoting Activities. Heliyon 2024, 10, e31573. [Google Scholar] [CrossRef]
- Glick, B.R. Plant Growth-Promoting Bacteria: Mechanisms and Applications. Scientifica 2012, 2012, 963401. [Google Scholar] [CrossRef]
- Timmusk, S.; Behers, L.; Muthoni, J.; Muraya, A.; Aronsson, A.C. Perspectives and Challenges of Microbial Application for Crop Improvement. Front. Plant Sci. 2017, 8, 49. [Google Scholar] [CrossRef]
- Müller, D.B.; Vogel, C.; Bai, Y.; Vorholt, J.A. The Plant Microbiota: Systems-Level Insights and Perspectives. Annu. Rev. Genet. 2016, 50, 211–234. [Google Scholar] [CrossRef]
- Pacifico, D.; Squartini, A.; Crucitti, D.; Barizza, E.; Lo Schiavo, F.; Muresu, R.; Carimi, F.; Zottini, M. The Role of the Endophytic Microbiome in the Grapevine Response to Environmental Triggers. Front. Plant Sci. 2019, 10, 1256. [Google Scholar] [CrossRef]
- Dastogeer, K.M.G.; Tumpa, F.H.; Sultana, A.; Akter, M.A.; Chakraborty, A. Plant Microbiome–an Account of the Factors That Shape Community Composition and Diversity. Curr. Plant Biol. 2020, 23, 100161. [Google Scholar] [CrossRef]
- Cardoni, M.; Mercado-Blanco, J. Confronting Stresses Affecting Olive Cultivation from the Holobiont Perspective. Front. Plant Sci. 2023, 14, 1261754. [Google Scholar] [CrossRef]
- FAO. FAOSTAT Crops and Livestock Products Database. Available online: https://www.fao.org/faostat/en/#data/QCL (accessed on 3 January 2025).
- Marchese, A.; Bonanno, F.; Marra, F.P.; Trippa, D.A.; Zelasco, S.; Rizzo, S.; Giovino, A.; Imperiale, V.; Ioppolo, A.; Sala, G.; et al. Recovery and Genotyping Ancient Sicilian Monumental Olive Trees. Front. Conserv. Sci. 2023, 4, 1206832. [Google Scholar] [CrossRef]
- Ferraro, V.; Conigliaro, G.; Torta, L.; Burruano, S.; Moschetti, G. Preliminary Investigation on the Endophytic Communities in Olea europaea L. in Sicily. In Proceedings of the 7th International Conference on Integrated Fruit Production, Avignon, France, 27–30 October 2008; pp. 459–463. [Google Scholar]
- Gomes, T.; Pereira, J.A.; Benhadi, J.; Lino-Neto, T.; Baptista, P. Endophytic and Epiphytic Phyllosphere Fungal Communities Are Shaped by Different Environmental Factors in a Mediterranean Ecosystem. Microb. Ecol. 2018, 76, 668–679. [Google Scholar] [CrossRef] [PubMed]
- Mina, D.; Pereira, J.A.; Lino-Neto, T.; Baptista, P. Epiphytic and Endophytic Bacteria on Olive Tree Phyllosphere: Exploring Tissue and Cultivar Effect. Microb. Ecol. 2020, 80, 145–157. [Google Scholar] [CrossRef] [PubMed]
- Crucitti, D.; Barone, S.; Carimi, F.; Caruso, T.; Pacifico, D. Host and Environmental Factors Shape the Endophytic Diversity and Composition of Sicilian Phyllosphere Olive Trees [Conference Presentation]. In Proceedings of the V Convegno AISSA #UNDER40, Firenze, Italy, 26 June 2024; p. 193. [Google Scholar]
- Manici, L.M.; Caputo, F.; Castellini, M.; Saccà, M.L. Binucleate Rhizoctonia Sp. AG-A, Indigenous Plant-Growth Promoting Fungus in Semi-Arid Mediterranean Soils. Plant Soil 2023, 483, 379–393. [Google Scholar] [CrossRef]
- Porter, S.S.; Sachs, J.L. Agriculture and the Disruption of Plant–Microbial Symbiosis. Trends Ecol. Evol. 2020, 35, 426–439. [Google Scholar] [CrossRef]
- Wentzien, N.M.; Fernández-González, A.J.; Villadas, P.J.; Valverde-Corredor, A.; Mercado-Blanco, J.; Fernández-López, M. Thriving beneath Olive Trees: The Influence of Organic Farming on Microbial Communities. Comput. Struct. Biotechnol. J. 2023, 21, 3575–3589. [Google Scholar] [CrossRef]
- Wilson, K. Preparation of Genomic DNA from Bacteria. Curr. Protoc. Mol. Bio 2001, 56, 2.4.1–2.4.5. [Google Scholar] [CrossRef]
- Lane, D.J. 16S/23S RRNA Sequencing. In Nucleic Acid Techniques in Bacterial Systematics; Stackebrandt, E., Goodfellow, M., Eds.; John Wiley and Sons: New York, NY, USA, 1991. [Google Scholar]
- Doyle, J.J.; Doyle, J.L. A Rapid DNA Isolation Procedure for Small Quantities of Fresh Leaf Tissue. Phytochem. Bull. 1987, 19, 11–15. [Google Scholar]
- White, T.J.; Bruns, T.; Lee, S.; Taylor, J. Amplification and Direct Sequencing of Fungal Ribosomal RNA Genes for Phylogenetics. In PCR Protocols: A Guide to Methods and Applications; Accademic Press Inc.: Cambridge, MA, USA, 1990; pp. 315–322. [Google Scholar]
- Stackebrandt, E.; Mondotte, J.A.; Fazio, L.L.; Jetten, M. Authors Need to Be Prudent When Assigning Names to Microbial Isolates. Antonie Van Leeuwenhoek Int. J. Gen. Mol. Microbiol. 2022, 115, 1–5. [Google Scholar] [CrossRef]
- Gordon, S.A.; Weber, R.P. Colorimetric Estimation of Indoleacetic Acid. Plant Physiol. 1951, 26, 192–195. [Google Scholar] [CrossRef]
- Schwyn, B.; Neilands, J.B. Universal Chemical Assay for the Detection and Determination of Siderophores. Anal. Biochem. 1987, 160, 47–56. [Google Scholar] [CrossRef]
- Nautiyal, C.S. An Efficient Microbiological Growth Medium for Screening Phosphate Solubilizing Microorganisms. FEMS Microbiol. Lett. 1999, 170, 265–270. [Google Scholar] [CrossRef] [PubMed]
- Döebereiner, J. Isolation and Identification of Aerobic Nitrogen-Fixing Bacteria from Soil and Plants. In Methods in Applied Soil Microbiology and Biochemistry; Alef, K., Nannipieri, P., Eds.; Academic Press: London, UK, 1995; pp. 134–141. [Google Scholar]
- del Castillo, I.; Hernández, P.; Lafuente, A.; Rodríguez-Llorente, I.D.; Caviedes, M.A.; Pajuelo, E. Self-Bioremediation of Cork-Processing Wastewaters by (Chloro) Phenol-Degrading Bacteria Immobilised onto Residual Cork Particles. Water Res. 2012, 46, 1723–1734. [Google Scholar] [CrossRef] [PubMed]
- Penrose, D.M.; Glick, B.R. Methods for Isolating and Characterizing ACC Deaminase-Containing Plant Growth-Promoting Rhizobacteria. Physiol. Plant 2003, 118, 10–15. [Google Scholar] [CrossRef]
- Harley, J.P.; Prescott, L.M. Laboratory Exercises in Microbiology, 5th ed.; The McGraw-Hill Companies: New York, NY, USA, 2002. [Google Scholar]
- Elbeltagy, A.; Nishioka, K.; Suzuki, H.; Sato, T.; Sato, Y.I.; Morisaki, H.; Mitsui, H.; Minamisawa, K. Isolation and Characterization of Endophytic Bacteria from Wild and Traditionally Cultivated Rice Varieties. Soil Sci. Plant Nutr. 2000, 46, 617–629. [Google Scholar] [CrossRef]
- Mesa, J.; Mateos-Naranjo, E.; Caviedes, M.A.; Redondo-Gómez, S.; Pajuelo, E.; Rodríguez-Llorente, I.D. Scouting Contaminated Estuaries: Heavy Metal Resistant and Plant Growth Promoting Rhizobacteria in the Native Metal Rhizoaccumulator Spartina Maritima. Mar. Pollut. Bull. 2015, 90, 150–159. [Google Scholar] [CrossRef]
- Yao, X.; Guo, H.; Zhang, K.; Zhao, M.; Ruan, J.; Chen, J. Trichoderma and Its Role in Biological Control of Plant Fungal and Nematode Disease. Front. Microbiol. 2023, 14, 1160551. [Google Scholar] [CrossRef]
- Chen, P.H.; Chen, R.Y.; Chou, J.Y. Screening and Evaluation of Yeast Antagonists for Biological Control of Botrytis cinerea on Strawberry Fruits. Mycobiology 2018, 46, 33–46. [Google Scholar] [CrossRef]
- Maluleke, E.; Jolly, N.P.; Patterton, H.G.; Setati, M.E. Antifungal Activity of Non-Conventional Yeasts against Botrytis cinerea and Non-Botrytis Grape Bunch Rot Fungi. Front. Microbiol. 2022, 13, 986229. [Google Scholar] [CrossRef]
- Higgins, J.J. Introduction to Modern Nonparametric Statistics; Crockett, C., Ed.; Brooks/Cole-Thomson Learning: Pacific Grove, CA, USA, 2004; ISBN 0-534-38775-6. [Google Scholar]
- Minitab LLC. Minitab. 2021. Available online: https://www.minitab.com (accessed on 3 January 2025).
- Hammer, Ø.; Harper, D.A.T.; Ryan, P.D. PAST: Paleontological Statistics Software Package for Education and Data Analysis. Palaeontol. Electron. 2001, 4, 1–9. [Google Scholar]
- Nguyen, N.H.; Song, Z.; Bates, S.T.; Branco, S.; Tedersoo, L.; Menke, J.; Schilling, J.S.; Kennedy, P.G. FUNGuild: An Open Annotation Tool for Parsing Fungal Community Datasets by Ecological Guild. Fungal. Ecol. 2016, 20, 241–248. [Google Scholar] [CrossRef]
- Lemanceau, P.; Blouin, M.; Muller, D.; Moënne-Loccoz, Y. Let the Core Microbiota Be Functional. Trends Plant Sci. 2017, 22, 583–595. [Google Scholar] [CrossRef] [PubMed]
- Costa, D.; Fernandes, T.; Martins, F.; Pereira, J.A.; Tavares, R.M.; Santos, P.M.; Baptista, P.; Lino-Neto, T. Illuminating Olea europaea, L. Endophyte Fungal Community. Microbiol. Res. 2021, 245, 126693. [Google Scholar] [CrossRef] [PubMed]
- Bulgari, D.; Casati, P.; Brusetti, L.; Quaglino, F.; Brasca, M.; Daffonchio, D.; Bianco, P.A. Endophytic Bacterial Diversity in Grapevine (Vitis Vinifera L.) Leaves Described by 16S RRNA Gene Sequence Analysis and Length Heterogeneity-PCR. J. Microbiol. 2009, 47, 393–401. [Google Scholar] [CrossRef] [PubMed]
- Materatski, P.; Varanda, C.; Carvalho, T.; Dias, A.B.; Campos, M.D.; Rei, F.; do Rosário Félix, M. Spatial and Temporal Variation of Fungal Endophytic Richness and Diversity Associated to the Phyllosphere of Olive Cultivars. Fungal Biol. 2019, 123, 66–76. [Google Scholar] [CrossRef]
- Sadeghi, F.; Samsampour, D.; Seyahooei, M.A.; Bagheri, A.; Soltani, J. Diversity and Spatiotemporal Distribution of Fungal Endophytes Associated with Citrus reticulata cv. Siyahoo. Curr. Microbiol. 2019, 76, 279–289. [Google Scholar] [CrossRef]
- Yarte, M.E.; Gismondi, M.I.; Llorente, B.E.; Larraburu, E.E. Isolation of Endophytic Bacteria from the Medicinal, Forestal and Ornamental Tree Handroanthus impetiginosus. Environ. Technol. 2022, 43, 1129–1139. [Google Scholar] [CrossRef]
- Hanani, A.; Valentini, F.; Sanzani, S.M.; Santoro, F.; Minutillo, S.A.; Gallo, M.; Cavallo, G.; Mourou, M.; El Moujabber, M.; D’onghia, A.M.; et al. Community Analysis of Culturable Sapwood Endophytes from Apulian Olive Varieties with Different Susceptibility to Xylella fastidiosa. Agronomy 2022, 12, 9. [Google Scholar] [CrossRef]
- Vaghari Souran, S.E.; Shekariesfahlan, A.; Ashrafi, F.; Naeimi, S.; Ghasemi, A. Isolation and Identification of Grapevine Endophytic Bacteria with Antagonistic Potential against Fomitiporia mediterranea, a Pathogen Involved in Grapevine Trunk Disease. J. Plant Dis. Prot. 2023, 130, 1371–1384. [Google Scholar] [CrossRef]
- Esmaeili, M.; Shahryari, F.; Sarikhani, S. Unveiling the Potential of Endophytic Bacteria in Combatting Walnut Bacterial Canker Disease. J. Plant Pathol. 2025, 107, 551–563. [Google Scholar] [CrossRef]
- Eevers, N.; Gielen, M.; Sánchez-López, A.; Jaspers, S.; White, J.C.; Vangronsveld, J.; Weyens, N. Optimization of Isolation and Cultivation of Bacterial Endophytes through Addition of Plant Extract to Nutrient Media. Microb. Biotechnol. 2015, 8, 707–715. [Google Scholar] [CrossRef]
- Rungjindamai, N.; Jones, E.B.G. Why Are There So Few Basidiomycota and Basal Fungi as Endophytes? A Review. J. Fungi 2024, 10, 67. [Google Scholar] [CrossRef] [PubMed]
- Neri, F.; Crucitti, D.; Negrini, F.; Pacifico, D.; Ceredi, G.; Carimi, F.; Lolas, M.A.; Collina, M.; Baraldi, E. New Insight into Morphological and Genetic Diversity of Phlyctema vagabunda and Neofabraea kienholzii Causing Bull’s Eye Rot on Apple and Pear. Plant Pathol. 2023, 72, 268–289. [Google Scholar] [CrossRef]
- Rashmi, M.; Kushveer, J.S.; Sarma, V.V. A Worldwide List of Endophytic Fungi with Notes on Ecology and Diversity. Mycosphere 2019, 10, 798–1079. [Google Scholar] [CrossRef]
- Bizos, G.; Papatheodorou, E.M.; Chatzistathis, T.; Ntalli, N.; Aschonitis, V.G.; Monokrousos, N. The Role of Microbial Inoculants on Plant Protection, Growth Stimulation, and Crop Productivity of the Olive Tree (Olea europea L.). Plants 2020, 9, 743. [Google Scholar] [CrossRef]
- Nicoletti, R.; Di Vaio, C.; Cirillo, C. Endophytic Fungi of Olive Tree. Microorganisms 2020, 8, 1321. [Google Scholar] [CrossRef]
- de Oliveira, A.A.; de Oliveira Ramalho, M.; Moreau, C.S.; de Carvalho Campos, A.E.; Harakava, R.; Bueno, O.C. Exploring the Diversity and Potential Interactions of Bacterial and Fungal Endophytes Associated with Different Cultivars of Olive (Olea europaea) in Brazil. Microbiol. Res. 2022, 263, 127128. [Google Scholar] [CrossRef]
- Girsowicz, R.; Moroenyane, I.; Steinberger, Y. Bacterial Seed Endophyte Community of Annual Plants Modulated by Plant Photosynthetic Pathways. Microbiol. Res. 2019, 223, 58–62. [Google Scholar] [CrossRef]
- Anguita-Maeso, M.; Olivares-García, C.; Haro, C.; Imperial, J.; Navas-Cortés, J.A.; Landa, B.B. Culture-Dependent and Culture-Independent Characterization of the Olive Xylem Microbiota: Effect of Sap Extraction Methods. Front. Plant Sci. 2020, 10, 1708. [Google Scholar] [CrossRef]
- Müller, H.; Berg, C.; Landa, B.B.; Auerbach, A.; Moissl-Eichinger, C.; Berg, G. Plant Genotype-Specific Archaeal and Bacterial Endophytes but Similar Bacillus Antagonists Colonize Mediterranean Olive Trees. Front. Microbiol. 2015, 6, 138. [Google Scholar] [CrossRef]
- Martins, F.; Pereira, J.A.; Bota, P.; Bento, A.; Baptista, P. Fungal Endophyte Communities in Above- and Belowground Olive Tree Organs and the Effect of Season and Geographic Location on Their Structures. Fungal Ecol. 2016, 20, 193–201. [Google Scholar] [CrossRef]
- Hanif, M.S.; Tayyab, M.; Baillo, E.H.; Islam, M.M.; Islam, W.; Li, X. Plant Microbiome Technology for Sustainable Agriculture. Front. Microbiol. 2024, 15, 1500260. [Google Scholar] [CrossRef] [PubMed]
- Banerjee, S.; Schlaeppi, K.; van der Heijden, M.G.A. Keystone Taxa as Drivers of Microbiome Structure and Functioning. Nat. Rev. Microbiol. 2018, 16, 567–576. [Google Scholar] [CrossRef] [PubMed]
- Jousset, A.; Bienhold, C.; Chatzinotas, A.; Gallien, L.; Gobet, A.; Kurm, V.; Küsel, K.; Rillig, M.C.; Rivett, D.W.; Salles, J.F.; et al. Where Less May Be More: How the Rare Biosphere Pulls Ecosystems Strings. ISME J. 2017, 11, 853–862. [Google Scholar] [CrossRef]
- Harrison, J.G.; Griffin, E.A. The Diversity and Distribution of Endophytes across Biomes, Plant Phylogeny and Host Tissues: How Far Have We Come and Where Do We Go from Here? Environ. Microbiol. 2020, 22, 2107–2123. [Google Scholar] [CrossRef]
- Petrini, O.; Sieber, T.N.; Toti, L.; Viret, O. Ecology, Metabolite Production, and Substrate Utilization in Endophytic Fungi. Nat. Toxins 1992, 1, 185–196. [Google Scholar] [CrossRef]
- Abdelfattah, A.; Li Destri Nicosia, M.G.; Cacciola, S.O.; Droby, S.; Schena, L. Metabarcoding Analysis of Fungal Diversity in the Phyllosphere and Carposphere of Olive (Olea europaea). PLoS ONE 2015, 10, e0131069. [Google Scholar] [CrossRef]
- Bhutani, N.; Maheshwari, R.; Negi, M.; Suneja, P. Optimization of IAA Production by Endophytic Bacillus Spp. from Vigna radiata for Their Potential Use as Plant Growth Promoters. Isr. J. Plant Sci. 2018, 65, 83–96. [Google Scholar] [CrossRef]
- Stavridou, E.; Karamichali, I.; Lagiotis, G.; Patsea, E.; Osathanunkul, M.; Madesis, P. Seasonal Shifts in Soil Microbiome Structure Are Associated with the Cultivation of the Local Runner Bean Variety around the Lake Mikri Prespa. Biology 2022, 11, 1595. [Google Scholar] [CrossRef]
- Vishwakarma, S.K.; Ilyas, T.; Shahid, M.; Malviya, D.; Kumar, S.; Singh, S.; Johri, P.; Singh, U.B.; Singh, H.V. Bacillus Spp.: Nature’s Gift to Agriculture and Humankind. In Applications of Bacillus and Bacillus Derived Genera in Agriculture, Biotechnology and Beyond; Mageshwaran, V., Singh, U.B., Saxena, A.K., Singh, H.B., Eds.; Springer: Singapore, 2024; Volume 51, pp. 1–36. ISBN 978-981-99-8195-3. [Google Scholar]
- Cesaro, P.; Gamalero, E.; Zhang, J.; Pivato, B. Editorial: The Plant Holobiont Volume I: Microbiota as Part of the Holobiont; Challenges for Agriculture. Front. Plant Sci. 2021, 12, 799168. [Google Scholar] [CrossRef]
- Sofo, A.; Ciarfaglia, A.; Scopa, A.; Camele, I.; Curci, M.; Crecchio, C.; Xiloyannis, C.; Palese, A.M. Soil Microbial Diversity and Activity in a Mediterranean Olive Orchard Using Sustainable Agricultural Practices. Soil Use Manag. 2014, 30, 160–167. [Google Scholar] [CrossRef]
- Dias, M.C.; Silva, S.; Galhano, C.; Lorenzo, P. Olive Tree Belowground Microbiota: Plant Growth-Promoting Bacteria and Fungi. Plants 2024, 13, 1848. [Google Scholar] [CrossRef] [PubMed]
- Melloni, R.; Cardoso, E.J.B.N. Microbiome Associated with Olive Cultivation: A Review. Plants 2023, 12, 897. [Google Scholar] [CrossRef]
- Aranda, S.; Montes-Borrego, M.; Jiménez-Díaz, R.M.; Landa, B.B. Microbial Communities Associated with the Root System of Wild Olives (Olea europaea L. subsp. suropaea var. sylvestris) Are Good Reservoirs of Bacteria with Antagonistic Potential against Verticillium dahliae. Plant Soil 2011, 343, 329–345. [Google Scholar] [CrossRef]
- Ahmed, E.; Holmström, S.J.M. Siderophores in Environmental Research: Roles and Applications. Microb. Biotechnol. 2014, 7, 196–208. [Google Scholar] [CrossRef]
- Ning, X.; Lin, M.; Huang, G.; Mao, J.; Gao, Z.; Wang, X. Research Progress on Iron Absorption, Transport, and Molecular Regulation Strategy in Plants. Front. Plant Sci. 2023, 14, 1190768. [Google Scholar] [CrossRef]
- Miethke, M.; Marahiel, M.A. Siderophore-Based Iron Acquisition and Pathogen Control. Microbiol. Mol. Biol. Rev. 2007, 71, 413–451. [Google Scholar] [CrossRef]
- Asaf, S.; Numan, M.; Khan, A.L.; Al-Harrasi, A. Sphingomonas: From Diversity and Genomics to Functional Role in Environmental Remediation and Plant Growth. Crit. Rev. Biotechnol. 2020, 40, 138–152. [Google Scholar] [CrossRef]
- Bouremani, N.; Cherif-Silini, H.; Silini, A.; Rabhi, N.E.H.; Bouket, A.C.; Belbahri, L. Osmotolerant Plant Growth Promoting Bacteria Mitigate Adverse Effects of Drought Stress on Wheat Growth. AIMS Microbiol. 2024, 10, 507–541. [Google Scholar] [CrossRef]
- Li, Y.; Narayanan, M.; Shi, X.; Chen, X.; Li, Z.; Ma, Y. Biofilms Formation in Plant Growth-Promoting Bacteria for Alleviating Agro-Environmental Stress. Sci. Total Environ. 2024, 907, 167774. [Google Scholar] [CrossRef]
- Zhou, L. Discovery of Natural Products from Bacilli and Pseudomonas for Biocontrol of Plant Diseases. Ph.D. Thesis, University of Groningen, Groningen, The Netherlands, 2021. [Google Scholar]
- Abdelwahed, S.; Trabelsi, E.; Saadouli, I.; Kouidhi, S.; Masmoudi, A.S.; Cherif, A.; Mnif, W.; Mosbah, A. A New Pioneer Colorimetric Micro-Plate Method for the Estimation of Ammonia Production by Plant Growth Promoting Rhizobacteria (PGPR). Main Group Chem. 2022, 21, 55–68. [Google Scholar] [CrossRef]
- Shukla, A.; Gupta, A.; Srivastava, S. Bacterial Consortium (Priestia endophytica NDAS01F, Bacillus licheniformis NDSA24R, and Priestia flexa NDAS28R) and Thiourea Mediated Amelioration of Arsenic Stress and Growth Improvement of Oryza sativa L. Plant Physiol. Biochem. 2023, 195, 14–24. [Google Scholar] [CrossRef] [PubMed]
- Gowtham, H.G.; Duraivadivel, P.; Ayusman, S.; Sayani, D.; Gholap, S.L.; Niranjana, S.R.; Hariprasad, P. ABA Analogue Produced by Bacillus marisflavi Modulates the Physiological Response of Brassica juncea L. under Drought Stress. Appl. Soil Ecol. 2021, 159, 103845. [Google Scholar] [CrossRef]
- Panpatte, D.G. Providencia vermicola AAU PR1- A New Bioinoculant for Agriculture with Multiple Utility. Indian J. Pure Appl. Biosci. 2020, 8, 185–194. [Google Scholar] [CrossRef]
- Aish, A.A.; Sulaiman, M.M.; Youssef, S.A.; Massoud, S.I. Providencia vermicola Mediated Growth Alteration and Inhibited Gall Formation on Tomato Plants Infected with the Root Knot Nematode Meloidogyne javancia. Plant Arch. 2019, 19, 3865–3873. [Google Scholar]
- Liba, C.M.; Ferrara, F.I.S.; Manfio, G.P.; Fantinatti-Garboggini, F.; Albuquerque, R.C.; Pavan, C.; Ramos, P.L.; Moreira-Filho, C.A.; Barbosa, H.R. Nitrogen-Fixing Chemo-Organotrophic Bacteria Isolated from Cyanobacteria-Deprived Lichens and Their Ability to Solubilize Phosphate and to Release Amino Acids and Phytohormones. J. Appl. Microbiol. 2006, 101, 1076–1086. [Google Scholar] [CrossRef]
- Shahid, M.; Ahmed, T.; Noman, M.; Javed, M.T.; Javed, M.R.; Tahir, M.; Shah, S.M. Non-Pathogenic Staphylococcus Strains Augmented the Maize Growth through Oxidative Stress Management and Nutrient Supply under Induced Salt Stress. Ann. Microbiol. 2019, 69, 727–739. [Google Scholar] [CrossRef]
- Jain, S.; Varma, A.; Choudhary, D.K. Perspectives on Nitrogen-Fixing Bacillus Species. In Soil Nitrogen Ecology-Soil Biology; Cruz, C., Choudhary, D.K., Vishwakarma, K., Varma, A., Eds.; Springer: Cham, Switzerland, 2021; Volume 62, pp. 359–369. [Google Scholar]
- Sharma, K.; Sharma, S.; Vaishnav, A.; Jain, R.; Singh, D.; Singh, H.B.; Goel, A.; Singh, S. Salt-Tolerant PGPR Strain Priestia endophytica SK1 Promotes Fenugreek Growth under Salt Stress by Inducing Nitrogen Assimilation and Secondary Metabolites. J Appl. Microbiol. 2022, 133, 2802–2813. [Google Scholar] [CrossRef]
- Radhakrishnan, R.; Hashem, A.; Abd Allah, E.F. Bacillus: A Biological Tool for Crop Improvement through Bio-Molecular Changes in Adverse Environments. Front. Physiol. 2017, 8, 106911. [Google Scholar] [CrossRef] [PubMed]
- Ajuna, H.B.; Lim, H.I.; Moon, J.H.; Won, S.J.; Choub, V.; Choi, S.I.; Yun, J.Y.; Ahn, Y.S. The Prospect of Hydrolytic Enzymes from Bacillus Species in the Biological Control of Pests and Diseases in Forest and Fruit Tree Production. Int. J. Mol. Sci. 2023, 24, 16889. [Google Scholar] [CrossRef]
- Ji, Z.; Ling, Z.; Zhang, Q.; Xu, J.; Chen, X.; Tong, Y. Study on the Inhibition of Bacillus licheniformis on Botryosphaeria berengeriana f. sp. piricola and Glomerella cingulata and Biocontrol Efficacy on Postharvest Apple Diseases. J. Fruit Sci. 2008, 25, 209–214. [Google Scholar]
- Liu, Z.Z.; Zhu, J.P.; Li, M.; Xue, Q.Q.; Zeng, Y.; Wang, Z.P. Effects of Freshwater Bacterial Siderophore on Microcystis and Anabaena. Biol. Control 2014, 78, 42–48. [Google Scholar] [CrossRef]
- Sulochana, M.B.; Jayachandra, S.Y.; Kumar, S.K.A. Antifungal Attributes of Siderophore Produced by the Pseudomonas aeruginosa JAS-25. J. Basic Microbiol. 2014, 54, 418–424. [Google Scholar] [CrossRef] [PubMed]
- Chowdappa, S.; Jagannath, S.; Konappa, N.; Udayashankar, A.C.; Jogaiah, S. Detection and Characterization of Antibacterial Siderophores Secreted by Endophytic Fungi from Cymbidium aloifolium. Biomolecules 2020, 10, 1412. [Google Scholar] [CrossRef]
- Khan, A.; Singh, P.; Kumar, R.; Das, S.; Singh, R.K.; Mina, U.; Agrawal, G.K.; Rakwal, R.; Sarkar, A.; Srivastava, A. Antifungal Activity of Siderophore Isolated From Escherichia coli Against Aspergillus nidulans via Iron-Mediated Oxidative Stress. Front. Microbiol. 2021, 12, 729032. [Google Scholar] [CrossRef]
- Suleimanova, A.D.; Sokolnikova, L.V.; Egorova, E.A.; Berkutova, E.S.; Pudova, D.S.; Khilyas, I.V.; Sharipova, M.R. Antifungal Activity of Siderophore Isolated from Pantoea brenneri Against Fusarium oxysporum. Russ. J. Plant Physiol. 2023, 70, 199. [Google Scholar] [CrossRef]
- Nigris, S.; Baldan, E.; Tondello, A.; Zanella, F.; Vitulo, N.; Favaro, G.; Guidolin, V.; Bordin, N.; Telatin, A.; Barizza, E.; et al. Biocontrol Traits of Bacillus licheniformis GL174, a Culturable Endophyte of Vitis vinifera cv. Glera. BMC Microbiol. 2018, 18, 1–16. [Google Scholar] [CrossRef]
- Medison, R.G.; Jiang, J.; Medison, M.B.; Tan, L.T.; Kayange, C.D.M.; Sun, Z.; Zhou, Y. Evaluating the Potential of Bacillus licheniformis YZCUO202005 Isolated from Lichens in Maize Growth Promotion and Biocontrol. Heliyon 2023, 9, e20204. [Google Scholar] [CrossRef]
Disclaimer/Publisher’s Note: The statements, opinions and data contained in all publications are solely those of the individual author(s) and contributor(s) and not of MDPI and/or the editor(s). MDPI and/or the editor(s) disclaim responsibility for any injury to people or property resulting from any ideas, methods, instructions or products referred to in the content. |
© 2025 by the authors. Licensee MDPI, Basel, Switzerland. This article is an open access article distributed under the terms and conditions of the Creative Commons Attribution (CC BY) license (https://creativecommons.org/licenses/by/4.0/).